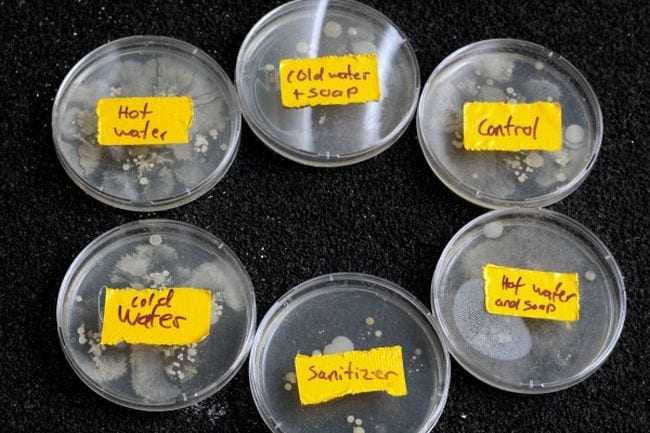

Looking for your next great science project? Look no further! These germ science projects and experiments for grades K-5 help students discover what germs really are and how we can protect ourselves against them. Get ready for some good clean science fun!
1. Build 3-D virus models

Have kids research various kinds of germs, like bacteria and viruses. Then provide a variety of materials and ask them to construct 3-D models of specific germs. Older kids can make more detailed models, like the impressive examples shown here. Younger kids can make simple models from Play-Doh like the ones at Reaching Happy.
2. Create edible bacteria models

Raid the kitchen for this germ science project! First, fill Petri dishes (or any small shallow containers) with Jell-O. As it starts to set, add various candies and nuts to represent different kinds of bacteria. Learn more from STEAMsational.
3. Use glitter to simulate germs

Anyone who’s ever used glitter for a craft project knows how very hard it is to get rid of once it’s out of the bottle. That’s what makes it the perfect stand-in for germs! Sprinkle glitter onto some students’ hands, being sure to get it under their nails and even on their wrists. Have them shake hands with other kids to see how germs spread, then head to the sink to try to wash all the glitter off. It takes real effort! Find out more from Gift of Curiosity or check out our video in action here!
4. Sprinkle toys with flour “germs”

Don’t want to risk glitter contamination of your entire classroom? Try this demo with flour or cornstarch instead. Start by sprinkling it on some toys, then asking one student to pick up the toy for a few seconds. Afterward, have them look at their own hands, imagining that the flour is germs spreading. You can have other kids play with the toys or shake hands too. This is a good start to a more complete discussion on germs and handwashing.
5. Show the effects of soap

This is one of our germ science projects that also teaches kids about surface tension. Sprinkle glitter on the surface of a shallow dish of water to represent germs. Drip a few drops of dish soap on the surface, and watch as the glitter germs spread to the side. Explain that the soap breaks up the surface tension holding the glitter in place, and that’s one reason it helps clean your hands too. Explore this project at Living Life & Learning.
6. Learn the best way to clean your hands
Have kids try a variety of handwashing methods like hand sanitizer, water alone, hot water and soap, and so on, then touch their fingers to the agar on a petri dish. Allow the dishes to sit for a few days to see the results. Discover the details at STEAMsational.
7. Use bread instead of Petri dishes

You don’t need specialized equipment for a good germ science experiment. Try it with bread instead! One teacher’s class was downright horrified by just how dirty their Chromebooks were, as this Buzzfeed article attests. Try it for yourself and find out where the dirtiest spots in your classroom are!
8. Try Bill Nye’s mask experiment

Bill Nye went viral (well, not literally) when he posted this TikTok video demonstrating the effectiveness of face masks. Recreate the experiment yourself, and talk about how some germs spread by breathing, sneezing, or coughing rather than touching surfaces or other people.
9. Simulate an immune system response

If germs do manage to make it into our bodies, the immune system is ready and waiting! Try this experiment with salt, iron filings, and magnetic tape to learn how antibodies bind to invading pathogens. Students will see the initial immune system response and the stronger secondary response, which is a great way to explain how vaccines work too. See how it’s done at Science Buddies.
10. Make those germs glow!
Glo Germ Gel is worth its weight in gold when it comes to showing kids how effective their handwashing is. Let them wash their hands and then have them apply the gel-like lotion. Under ultraviolet light, they can see all the places they missed… and pay extra attention to them the next time they go to wash!
